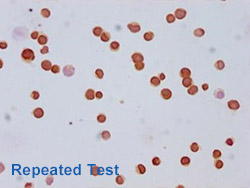
Acetyl-HIST1H3A Antibody Applied in IHC 02
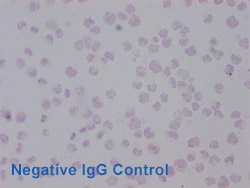
Acetyl-HIST1H3A Antibody Applied in IHC 12
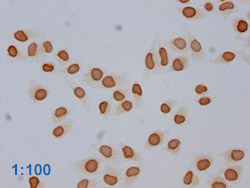
Acetyl-HIST1H3A Antibody Applied in IHC 14
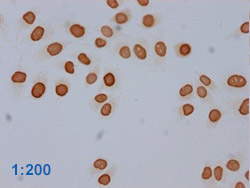
Acetyl-HIST1H3A Antibody Applied in IHC 15
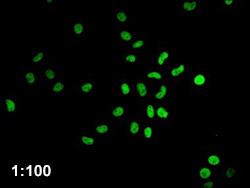
HIST1H4A Antibody Applied in IF 08
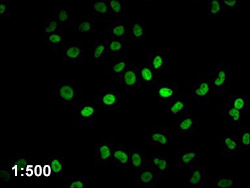
HIST1H4A Antibody Applied in IF 10
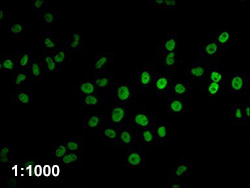
HIST1H4A Antibody Applied in IF 11

CUSABIO antibodies have been validated in multiple applications, and in order to show our application criterion more intuitively, we randomly selected two antibodies and used for all following applications.



Positive group: Hela whole cell lysate, Jurkat whole cell lysate, HEK293, HepG2 whole cell lysate (treated with 30mM sodium butyrate for 4h).
Control group: Hela whole cell lysate, Jurkat whole cell lysate, HEK293, HepG2 whole cell lysate (without any treatment).
Detected both positive and control groups firstly, then repeated the test, which showing good specificity and reproducibility.
Diluted Hela whole cell lysate at 1:1000 for testing again, which showing good sensitivity.
HEK293

Hela cells



HepG2 cells



Jurkat cells

Stained in HEK293, Hela cells, HepG2 cells, Jurkat cells, diluted at 1:100, repeated the test, chose IgG as negative control, which showing good specificity and reproducibility.

Stained in Hela cells and diluted from 1:50 to 1:1000, which showing good sensitivity.
Hela cells


HepG2 cells


HEK293


Stained in Hela cells, HepG2 cells and HEK293, diluted at 1:100, then repeated the test, which showing good specificity and reproducibility.

Stained in Hela cells and diluted from 1:50 to 1:1000, which showing good sensitivity.



Positive group: HIST1H3A proteins(20ug)
Negative group: Non-specific rabbit IgG (3ug)
Detected Hela cells firstly, repeated the test again, which showing good specificity and reproducibility.
Detected target antibodies with different loading amounts (3ug, 1ug, 0.5ug), compared with positive and negative groups, which showing good sensitivity.


Stained in Hela cells and Jurkat cells (red lines), chose Rabbit IgG control as isotype control (green lines), reacted under the same condition, which showing good specificity and reproducibility.


Positive group: Hela cells (treated with 30mM sodium butyrate for 4h)
Negative group: Hela cells (without any treatment)
Detected positive group for the first time, repeated the test with positive and negative groups again, loaded positive group with different amounts, chose normal rabbit IgG as control, which showing good specificity, sensitivity and reproducibility.